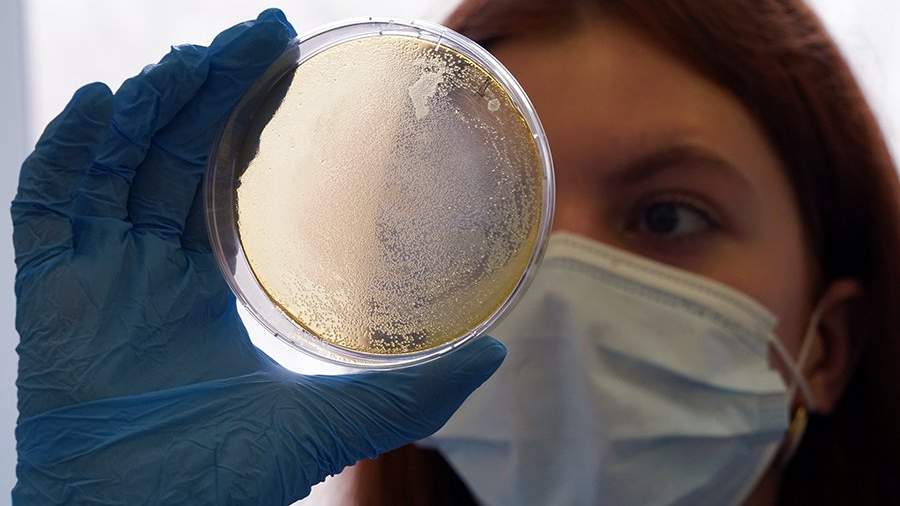

Врач рассказал о последствиях заражения паразитами
Паразиты в человеческом организме могут привести к дефициту питательных веществ, а также к жизнеугрожающим состояниям. Об этом в четверг, 8 июня, рассказал «Газете.Ru» инфекционист, главный врач клинико-диагностической лаборатории ООО «ИНВИТРО-Сибирь» Андрей Поздняков.
По его словам, определить наличие паразитов в организме может только врач по результатам анализов крови и кала.
«Проверяться стоит, только если есть определенный сиптомокомплекс и эозинофилия, то есть обоснованные подозрения на паразитоз. Если нет никакой симптоматики и ничего не беспокоит, то смысла проверяться нет», — сообщил врач.
Поздняков отметил, что заражению паразитами в одинаковой степени подвержены все люди вне зависимости от возраста и наличия патологий. Врач считает, что всё зависит от соблюдения правил гигиены и выбора продуктов для пищи. Также имеет значение профессиональная деятельность человека.
Инфекционист привел в пример людей, которые едят речную рыбу в слабосоленом виде и сырое мясо. У них риск заразиться описторхозом будет гораздо выше. Кроме того, подвержены риску заболеть гельминтозом люди, чья работа связана с землей.
«Паразитарных инвазий много, возможностей ими заразиться тоже, чаще всего путь передачи — фекально-оральный, когда яйца паразита попадают в рот через грязные руки или иным способом, например через продукты. Дети раннего возраста очень часто таскают руки в рот и риск заразиться инвазиями типа остриц и аскарид у них выше, чем у взрослого», — сказал эксперт.
Поздняков добавил, что наличие паразитов в организме приводит к определенным последствиям. Например, они съедают часть питательных веществ, витаминов. Паразитозы приводят к дефициту необходимых для человека веществ.
Кроме того, могут возникать и жизнеугрожающие состояния. Например, описторхисы, живущие в желчных путях до 25 лет, повышают риск развития злокачественных опухолей, в частности холангиокарциномы (рака желчных путей).
Врач заключил, что тяжесть любой паразитарной инвазии зависит от массивности паразитов и от своевременности их выявления.
Ранее, 10 мая, врач-диетолог «СМ-Клиники» кандидат медицинских наук Оксана Михалева сообщила, что употребление в пищу мяса с кровью может привести к заражению сальмонеллезом, кишечной палочкой и паразитарными заболеваниями.




